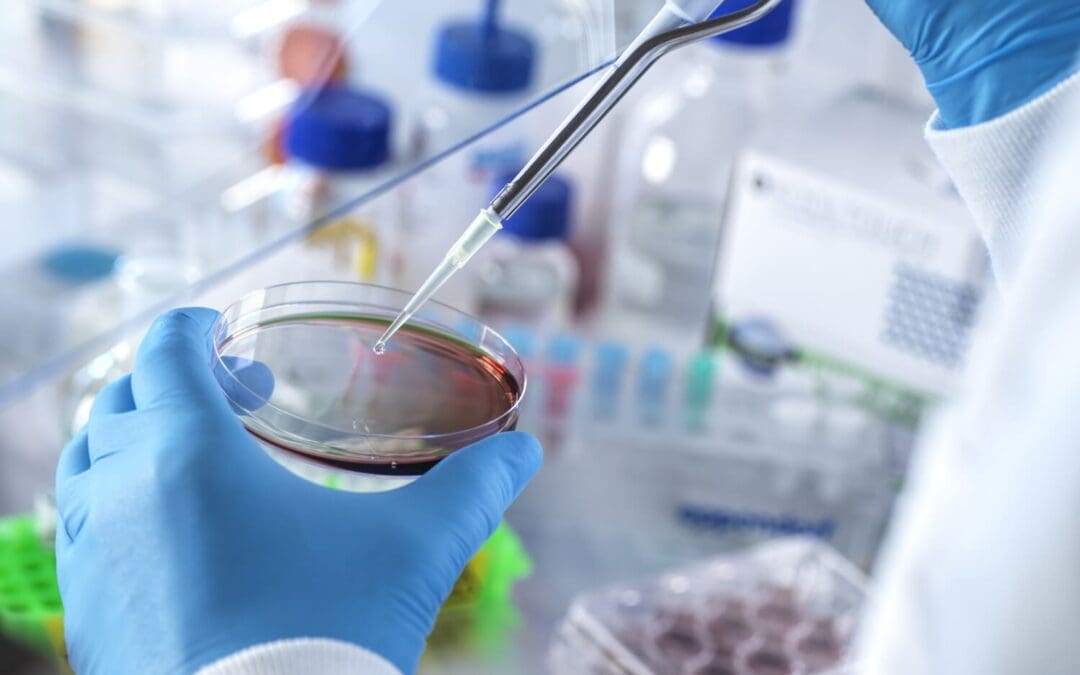
Is a Phlebotomist the Same as a Medical Lab Assistant?

by John Mah | Mar 19, 2026 | Medical Lab Assistant
Information is the lifeblood of healthcare, that’s why before a doctor makes a diagnosis, lab tests confirm what is going on inside the body. Behind these tests are skilled medical lab assistants. If you’re looking for a career in the healthcare field but prefer to...

by John Mah | Mar 11, 2026 | Medical Lab Assistant
When hiring lab assistants, employers need more than just good grades. They need to see that you can walk into a lab and get the job done safely, accurately, and under control. That’s where a medical laboratory assistant program in BC with hands-on training can really...

by John Mah | Mar 5, 2026 | Medical Lab Assistant
If you’re asking whether a BC medical lab assistant program is hard, the honest answer is this: it is challenging, but it is manageable, even if you are starting with no healthcare background. The challenge does not come from impossible material. It comes from...

by John Mah | Jan 27, 2026 | Medical Lab Assistant
Many people confuse phlebotomists with medical laboratory assistants, as they sometimes work in the same place (often healthcare labs). However, they aren’t the same job, because they don’t have the same duties, training, or career paths. If you are looking at...

by John Mah | Oct 29, 2025 | Medical Lab Assistant
When your doctor orders blood work to check your health, a medical laboratory assistant in BC collects your sample. When test results reveal what’s wrong and guide your treatment, a lab assistant processes that specimen. When hospitals identify infections before...

by John Mah | Oct 21, 2025 | Medical Lab Assistant
If you are already registered in a laboratory assistant course or are interested in becoming a professional in this field, at some point, you probably wondered about your future career and the paths you can follow. To help you decide on an area to follow, we have...